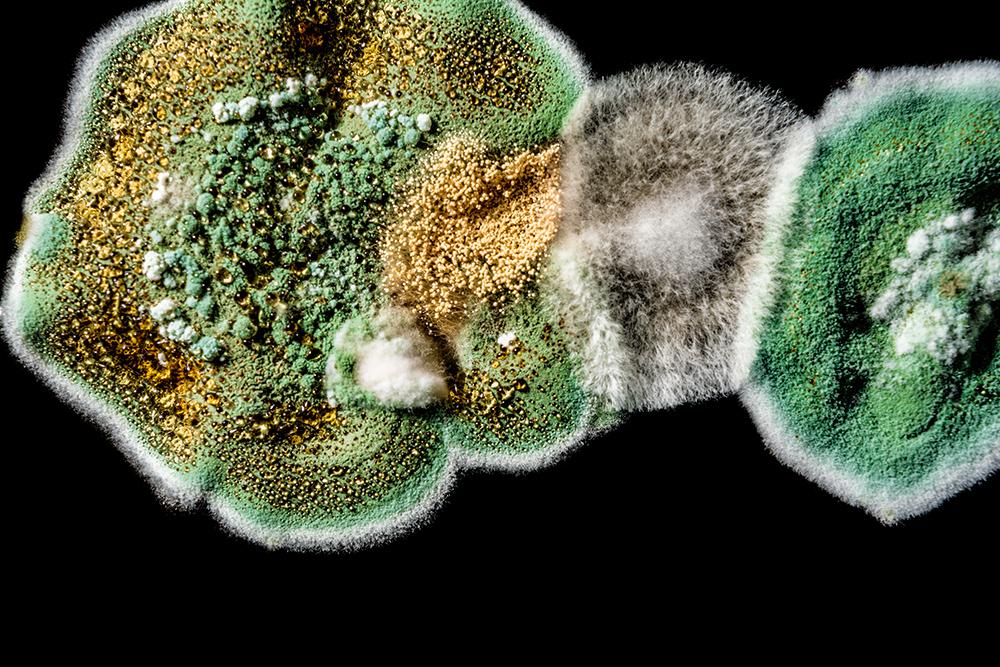
Fungus yields potent new cancer drug

Fungus yields potent new cancer drug
30 Jun 2025 by Ted Escobedo 1 min read
In a remarkable twist of science, researchers have transformed a fungus long associated with death into a potential weapon against cancer. Found in tombs like that of King Tut, Aspergillus flavus was once feared for its deadly spores. Now, scientists at Penn and several partner institutions have extracted a new class of molecules from it—called asperigimycins—that show powerful effects against leukemia cells. These compounds, part of a rare group known as fungal RiPPs, were bioengineered for potency and appear to disrupt cancer cell division with high specificity
Penn-led researchers have turned a deadly fungus into a potent cancer-fighting compound. After isolating a new class of molecules from Aspergillus flavus, a toxic crop fungus linked to deaths in the excavations of ancient tombs, the researchers modified the chemicals and tested them against leukemia cells. The result? A promising cancer-killing compound that rivals FDA-approved drugs and opens new frontiers in the discovery of more fungal medicines.
"Fungi gave us penicillin," says Sherry Gao, Presidential Penn Compact Associate Professor in Chemical and Biomolecular Engineering (CBE) and in Bioengineering (BE) and senior author of a new paper in Nature Chemical Biologyon the findings. "These results show that many more medicines derived from natural products remain to be found."
Know more: https://www.sciencedaily.com/releases/2025/06/2506...
IMAGE: © nnorozoff, 123RF Free Images
- Tags:
- News